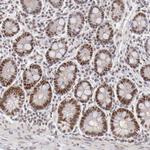
TFAP4 Antibody in Immunohistochemistry (Paraffin) (IHC (P))

Search
Invitrogen
TFAP4 Polyclonal Antibody
{{$productOrderCtrl.translations['antibody.pdp.commerceCard.promotion.promotions']}}
{{$productOrderCtrl.translations['antibody.pdp.commerceCard.promotion.viewpromo']}}
{{$productOrderCtrl.translations['antibody.pdp.commerceCard.promotion.promocode']}}: {{promo.promoCode}} {{promo.promoTitle}} {{promo.promoDescription}}. {{$productOrderCtrl.translations['antibody.pdp.commerceCard.promotion.learnmore']}}
产品信息
PA5-51658
种属反应
宿主/亚型
分类
类型
抗原
偶联物
形式
浓度
规格
纯化类型
保存液
内含物
保存条件
运输条件
RRID
产品详细信息
Immunogen sequence: YFMVPTQKVP SLQHFRKTEK EVIGGLCSLA NIPLTPETQR DQERRIRREI ANSNERRRMQ SINAGFQSLK TLIPHTDGEK LSKAAILQQT AEYIFSLEQE KTRLLQQNTQ LKRFIQELSG SSPKRRRAED KDEGIGSPDI WEDEK
Highest antigen sequence identity to the following orthologs: Mouse - 100%, Rat - 100%.
靶标信息
Transcription factors of the basic helix-loop-helix-zipper(bHLH-ZIP) family contain a basic domain, which is used for DNA binding, and HLH and ZIP domains, which are used for oligomerization. Transcription factor AP4 activates both viral and cellular genes by binding to the symmetrical DNA sequence CAGCTG.
仅用于科研。不用于诊断过程。未经明确授权不得转售。
篇参考文献 (0)
生物信息学
蛋白别名: Activating enhancer-binding protein 4; basic helix-loop-helix DNA-binding protein; bHLHc41; Class C basic helix-loop-helix protein 41; TFAP4; Transcription factor AP-4; transcription factor AP-4 (activating enhancer binding protein 4)
基因别名: AP-4; BHLHC41; TFAP4
UniProt ID: (Human) Q01664
Entrez Gene ID: (Human) 7023